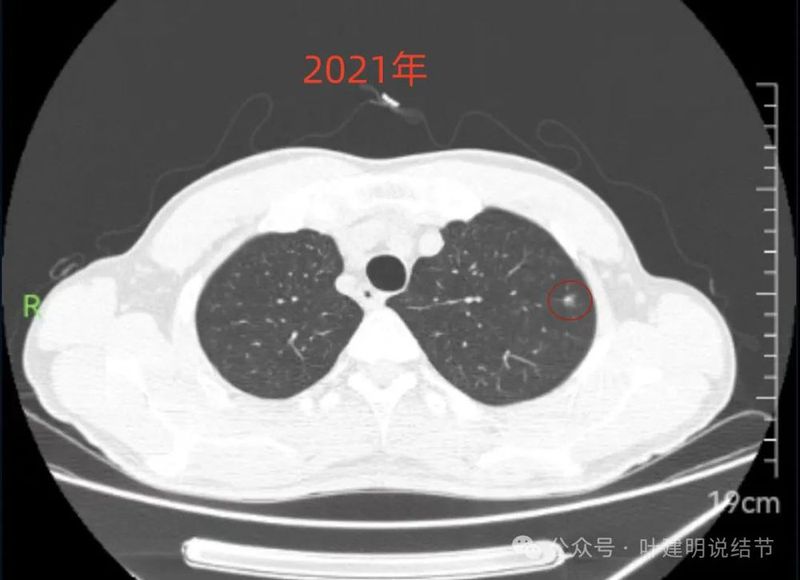
图片

前言:查出肺结节最怕什么?一是最怕是恶性的;二是最怕恶性的已经是浸润性了;三是怕浸润性癌已经不是早期了!但是不是浸润性腺癌就等于必风险很高会转移复发呢?显然并不是!除了病理上的类型与亚型,个人觉得有一点来评估预后比病理更可靠,那就是——随访进展情况!试想如果发现几年都不长的肺癌即使最后病理是浸润性癌,难道它不长个,就往外转移?这有,但肯定是少数!如果恶性程度高,不单表现为容易转移,也容易表现为局部的增大进展。今天分享的这个病例就是肺结节,网络问诊后我是觉得风险不高,虽肿瘤范畴,但再随访也可行。但术后反馈却已经是浸润性腺癌!
第一次问诊:2023年11月
病史信息:
基本信息:
男性, 41岁。
主诉:
检查发现肺结节5年。
现病史:
患者于2018年胸部CT检查发现双肺多发结节;后一直定期复查;于2023年10月在某市人民医院胸部CT检查;双肺多发结节,较大者位于右肺中叶内段,大小约7x6mm;医院医生建议手术。患者无特殊不适。拟进一步治疗,特网上问诊。
希望获得的帮助:
进展到什么阶段了,可以复查还是是否需要手术,如果需要手术,是左肺还是右肺手术?
影像展示与分析:
先看不同时间的明显层面截图:

2019年9月时右中叶磨玻璃密度病灶,轮廓与边界清楚,没有实性成分,中间密度稍低,考虑肿瘤范畴的,原位癌或微浸润性腺癌可能性较大。

2019年9月左上叶的磨玻璃结节,轮廓稍显模糊,有血管贴边,膨胀性不足。似乎更符合良性点。

2021年6月右中叶病灶,较前无明显变化。

2023年10月时右侧病灶没有明显进展。

2023年10月时左侧病灶较前略明显,便仍觉得密度从高到低有移行,由于整体轮廓较前明显,恶性的可能性增加了。
我的意见:
红色的就是报告上所主要的病灶,右肺中叶的,这个病灶是磨玻璃结节,整体轮廓清楚,瘤肺边界也清,是要考虑是肿瘤范畴的。但是它密度低,没有实性成分,目前风险还不大,还没有到一定要干预的程度,或许在观察三年5年8年也不见得一定会进展。我的想法是再观察一下,半年到一年之间复查都可以。蓝色的界限欠清,实性部分密度过高,像炎性点。意见供参考!
第二次问诊:2024年3月
病史情况:
疾病:
检查发现肺结节5年。
疾病描述:
叶主任您好:我2018年体检发现肺结节,上次2023年10月的检查请您看过,半年到了请您看看。最近分别是2024年1月份在上海某医院做的靶扫描,靶扫描是坚持左肺结节。2024年3月23日某医大附一院做的CT。请您帮助对比一下,变化情况。
问诊经历:
呼吸与危重症医学科:3次;中医科:2次;胸外科:8次;医学影像科:3次。
希望获得的帮助:
叶主任您好:根据靶扫描鉴别一下左肺结节良恶性,根据最新CT其他结节是否有变化。
影像展示与分析:
先看病灶较明显层面的截图:

2024年3月右侧病灶仍无明显两样。

2024年3月时左上病灶感觉密度更高了点。
左侧病灶连续层面:
2019年:

病灶处密度过高,似偏长条状。

此层见病灶有磨玻璃成分,但显得较为模糊。
2021年:

病灶上缘即偏实性,非圆形或类圆形。
边上有少许淡面模糊的磨玻璃成分。

轮廓欠清,瘤肺边界也不清晰。
2023年:

病灶出现,偏实性密度。

整体密度较高,且轮廓欠清。

感觉膨胀性不够。
2024年1月靶重建:

病灶密度较高,有月牙铲征,轮廓显模糊。

有微小血管,密度较高,有偏实性成分,磨玻璃密度淡,边界稍糊。

似乎密度过高,毛刺不是太锐利。

密度太高,而且偏长条状。

边缘区密度高,条状。

实性部分密度过高,磨玻璃部分密度淡且瘤肺边界不太清。
右侧病灶连续层面:

病灶出现,密度较淡。

轮廓清楚,血管贴边,也有血管弯征,瘤肺边界清楚。

轮廓与边界清,没有明显实性成分。

中间的密度稍低于周围部位。

轮廓清楚,边缘不光滑。

边缘区较淡。
我的意见:
右中叶与左上叶的都考虑是肿瘤范畴的,对比其实2019年时就有,红色的是右中叶的,没有显著进展变化,考虑原位癌可能性较大;桔色的是左上叶的,略有进展,考虑慢性炎伴肺泡上皮不典型增生或肺泡上皮增生可能性大,近期风险仍不算大,我觉得可以先常规年度复查随访,若有进展再考虑干预处理,可楔形切除的。意见供参考!
2024年4月反馈:
患:叶主任,我右肺的结节三天前手术,快速病理居然是浸润了,完全超出我的预期,崩溃。
我:没事的,效果一样。
感悟:
这个病例的右中叶结节是纯磨玻璃密度,而且前后随访达5年,提供了影像资料的也有4年,基本上没有明显变化,再随访能有什么风险?虽然不知道结友为什么最后仍选择了手术,大概是头牌医院的教授建议其手术。当然从事后来看,病理是浸润性腺癌了,手术是非常符合原则的,但在近年来越来越多磨玻璃密度的肺结节术后被诊断为浸润性腺癌,而确实又多年随访也不进展的类型,我总在想:我们目前病理诊断的标准对于磨玻璃肺癌是不是适合?按理说惰性到如此例5年都不进展的,当然可以继续观察,但它又确实按目前的病理诊断标准是达到浸润性腺癌的。其实是会造成结友的焦虑、恐慌与有时候过度治疗的。再一个问题,我是在想,病理标本也是人看的,人来判断的,不同医院、不同病理科医生的判定有出入是真实存在的,是否真的是浸润性?或许换个医生又诊断为微浸润性了,这是完全可能的。所以病理仍得与影像以及随访是否发展相结合来判断结节的风险程度,而不能只凭病理报告作为唯一的依据与最高准则。再次,从本例来看,虽然我第一次问诊时考虑左侧慢性炎可能性大,最多伴肺泡上皮增生可能性大,但第二次时因看了靶扫描影像,综合评估后是觉得也要考虑恶性。而若真恶性,显然左侧的风险要高于右中叶的这处纯磨玻璃结节的。但不知道为什么手术先做了右侧的?或许左侧认为是良性吧!